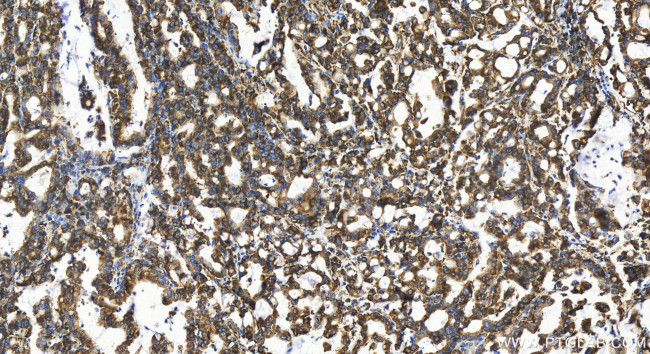
RPL18A Antibody in Immunohistochemistry (Paraffin) (IHC (P))

Search
Proteintech
RPL18A Recombinant Rabbit Monoclonal Antibody (240841B1)
{{$productOrderCtrl.translations['antibody.pdp.commerceCard.promotion.promotions']}}
{{$productOrderCtrl.translations['antibody.pdp.commerceCard.promotion.viewpromo']}}
{{$productOrderCtrl.translations['antibody.pdp.commerceCard.promotion.promocode']}}: {{promo.promoCode}} {{promo.promoTitle}} {{promo.promoDescription}}. {{$productOrderCtrl.translations['antibody.pdp.commerceCard.promotion.learnmore']}}
产品信息
83928-1-RR
种属反应
宿主/亚型
Expression System
分类
类型
克隆号
抗原
偶联物
形式
浓度
纯化类型
保存液
内含物
保存条件
运输条件
产品详细信息
Immunogen sequence: MKASGTLRE YKVVGRCLPT PKCHTPPLYR MRIFAPNHVV AKSRFWYFVS QLKKMKKSSG EIVYCGQVFE KSPLRVKNFG IWLRYDSRSG THNMYREYRD LTTAGAVTQC YRDMGARHRA RAHSIQIMKV EEIAASKCRR PAVKQFHDSK IKFPLPHRVL RRQHKPRFTT KRPNTFF
靶标信息
Ribosomes, the organelles that catalyze protein synthesis, consist of a small 40S subunit and a large 60S subunit. Together these subunits are composed of 4 RNA species and approximately 80 structurally distinct proteins. This gene encodes a member of the L18AE family of ribosomal proteins that is a component of the 60S subunit. The encoded protein may play a role in viral replication by interacting with the hepatitis C virus internal ribosome entry site (IRES). This gene is co-transcribed with the U68 snoRNA, located within the third intron. As is typical for genes encoding ribosomal proteins, there are multiple processed pseudogenes of this gene dispersed throughout the genome.
仅用于科研。不用于诊断过程。未经明确授权不得转售。
篇参考文献 (0)
生物信息学
蛋白别名: 60S ribosomal protein L18a; Large ribosomal subunit protein eL20; ribosomal protein L18a-like protein
基因别名: 2510019J09Rik; L18A; RPL18A
UniProt ID: (Human) Q02543, (Rat) P62718, (Mouse) P62717
Entrez Gene ID: (Human) 6142, (Rat) 290641, (Mouse) 76808